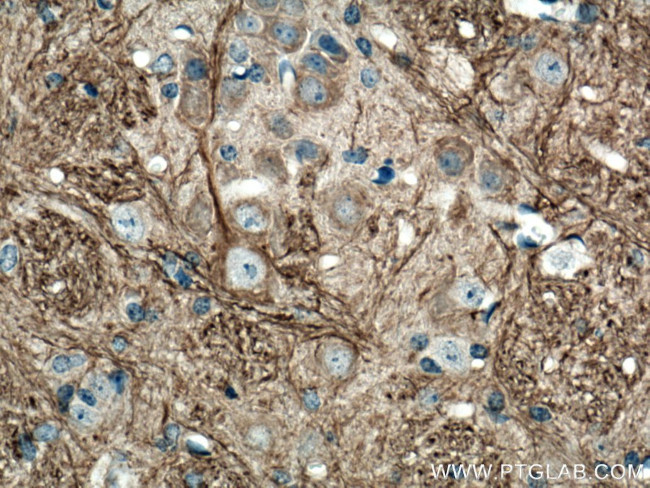
NF-M Antibody in Immunohistochemistry (Paraffin) (IHC (P))

Search
Proteintech
NF-M Polyclonal Antibody
{{$productOrderCtrl.translations['antibody.pdp.commerceCard.promotion.promotions']}}
{{$productOrderCtrl.translations['antibody.pdp.commerceCard.promotion.viewpromo']}}
{{$productOrderCtrl.translations['antibody.pdp.commerceCard.promotion.promocode']}}: {{promo.promoCode}} {{promo.promoTitle}} {{promo.promoDescription}}. {{$productOrderCtrl.translations['antibody.pdp.commerceCard.promotion.learnmore']}}
产品信息
25805-1-AP
种属反应
已发表种属
宿主/亚型
分类
类型
抗原
偶联物
形式
浓度
规格
纯化类型
保存液
内含物
保存条件
运输条件
产品详细信息
This antibody recognizes endogenous NF-M protein.
Immunogen sequence: MSYTLDSLG NPSAYRRVTE TRSSFSRVSG SPSSGFRSQS WSRGSPSTVS SSYKRSMLAP RLAYSSAMLS SAESSLDFSQ SSSLLNGGSG PGGDYKLS (1-97 aa encoded by BC002421)
靶标信息
Neurofilaments (NFs) are a type of intermediate filament (IF) expressed almost exclusively in neuronal cells, and in those cells most prominently in large axons. NFs, in most vertebrates, are composed of three different polypeptide chains with different molecular weights - neurofilament medium protein (NF-M), high (NF-H) and light protein (NF-L), which share sequence and structural similarity in a coiled-coil core domain, but differ in the length and sequence of their N-termini and more dramatically of their C-termini which in the case of NF-M and NF-H form the flexible extensions that link NFs to each other and to other elements in the cytoplasm. NF-M protein tail-mediated interactions of neurofilaments are critical for size and cytoskeletal architecture of axons, and are mediated, in part, by the highly phosphorylated tail domain of this protein. NF-M phosphorylation and O-GlcNAcylation are regulated reciprocally and affect its translocation and filament formation and function. Antibodies to the various neurofilament subunits are very useful cell type markers since the proteins are among the most abundant of the nervous system, are expressed only in neurons and are biochemically very stable.
仅用于科研。不用于诊断过程。未经明确授权不得转售。
生物信息学
蛋白别名: 160 kDa neurofilament protein; NEFM; Neurofilament 3; neurofilament 3, medium; Neurofilament medium polypeptide; neurofilament protein M; Neurofilament protein, middle polypeptide; Neurofilament triplet M protein; neurofilament triplet M protein; 160 KD neurofilament protein, NF-M; neurofilament, medium polypeptide 150kDa; neurofilament-3 (150 kD medium); neurofilament-M; NF-M; NMC; unnamed protein product
基因别名: NEF3; NEFM; NF-M; NF160; NF165; NFM
UniProt ID: (Human) P07197, (Mouse) P08553, (Rat) P12839
Entrez Gene ID: (Human) 4741, (Mouse) 18040, (Rat) 24588